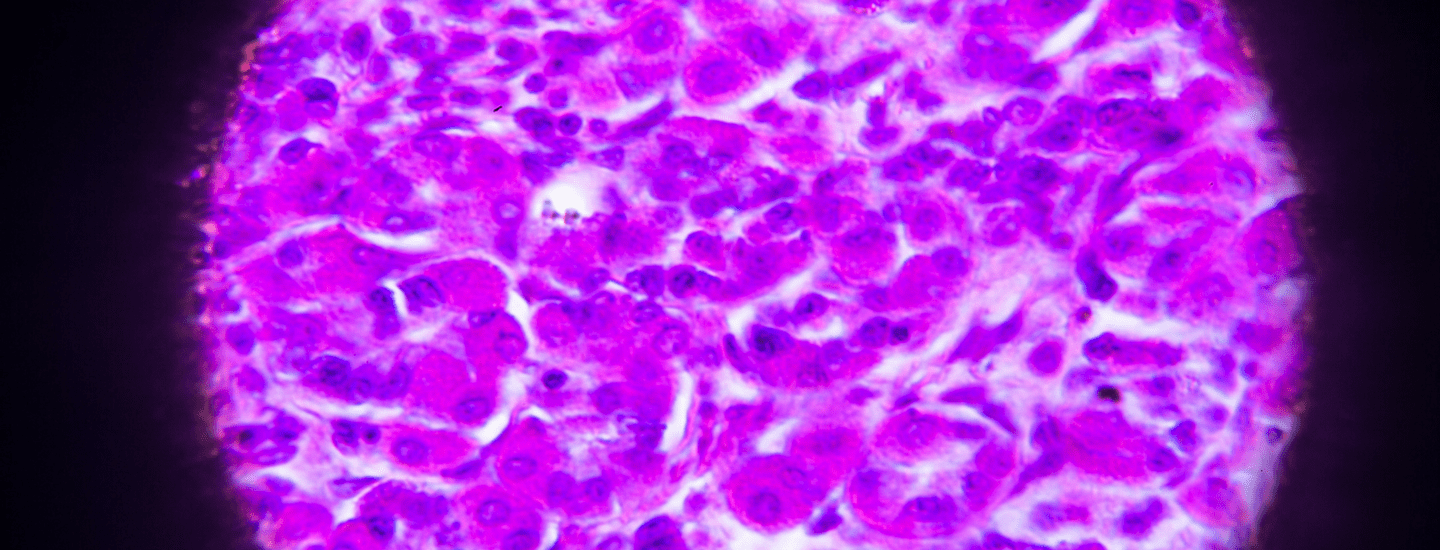

Stomach Cancer
Learn about stomach cancer
Stomach Cancer (also called gastric cancer) is a disease in which malignant cancer cells form in the lining of the stomach.
Stomach Cancer can develop in any part of the stomach, a J-shaped organ in the upper abdomen where digestion commences before food passes to the intestines. It is thought to develop slowly over many years.
When muscles in the stomach break down food, gastric juices are released from glands in the mucosa, which is the inner stomach layer. They turn food into a thick fluid and nutrients from this are absorbed through the small bowel’s walls into the bloodstream.
The wall of the stomach is made up of 3 layers of tissue:
- The innermost layer called the mucosal layer
- The middle layer called the muscularis layer
- The serosal layer which is the outermost layer
Around 90 to 95 per cent of Stomach Cancers develop in cells lining the mucosa – these are called adenocarcinomas, and they spread through the outer layers of the stomach. Other types include squamous cell carcinoma, lymphoma, stromal tumours, and carcinoid tumours, however these are rare.
As stomach cancer often doesn’t cause symptoms until the advanced stages, it is often detected at a later stage. Unusual changes in the stomach lining often preface stomach cancer.
It’s important to note that a number of conditions may cause these symptoms, not just Stomach Cancer.
- Indigestion and stomach discomfort
- A bloated feeling after eating
- Mild nausea
- Loss of appetite
- Heartburn
In more advanced stages of gastric cancer, the following symptoms may occur:
- Blood in the stool
- Vomiting
- Weight loss for no known reason
- Stomach pain
- Jaundice (yellowing of eyes and skin)
- Build-up of fluid in the abdomen
- Difficulty swallowing
Your GP should be consulted if any of these problems occur.
Diagnosing Stomach Cancer
Tests that are typically used to examine the stomach and oesophagus are used to diagnose stomach cancer. These include:
- Physical exam: checking for signs of the disease, such as lumps, pain or anything else that seems unusual.
- Blood chemistry studies: a procedure in which a blood sample is checked to measure the levels of certain substances released into the blood by organs and tissues in the body.
- Complete blood count (CBC) – checks for the following:
- The number of red blood cells, white blood cells, and platelets.
- The amount of haemoglobin (the protein that carries oxygen) in the red blood cells.
- Upper endoscopy: a procedure to look inside the oesophagus, stomach, and first part of the small intestine to check for abnormal areas.
- Faecal occult blood test: A test to check stool for blood.
- Barium swallow: The patient drinks a liquid that contains barium (a silver-white metallic compound). The liquid coats the oesophagus and stomach, and x-rays are taken.
- Biopsy: The removal of cells or tissues so they can be viewed under a microscope and checked for signs of cancer.
Stomach Cancer Treatment
Treatment will depend on how large the tumour has grown, how deeply it has invaded the stomach’s layers and whether it has spread to nearby organs, lymph nodes or other body parts.
Surgery is a common treatment in all stages of stomach cancer. The main treatment is gastrectomy surgery:
- Subtotal gastrectomy: removal of the part of the stomach that contains cancer, nearby lymph nodes and parts of other tissues and organs near the tumour. The spleen may also be removed.
- Total gastrectomy: The complete removal of the stomach, nearby lymph nodes and parts of the oesophagus, small intestine, and other tissues near the tumour. The spleen may be removed. The oesophagus is connected to the small intestine so the patient can continue to eat and swallow.
If the tumour is blocking the stomach but the cancer cannot be completely removed by standard surgery, the following procedures may be used:
- Endoluminal stent placement: a procedure to insert a stent (a thin, expandable tube) in order to keep a passage (such as the oesophagus) open.
- Endoluminal laser therapy: a procedure in which an endoscope (a thin, lighted tube) with a laser attached is inserted into the body.
Recent studies indicate a combination of surgery, chemotherapy and radiation offers the best chance of survival for stomach cancer patients.
Chemotherapy can be given when cancers have invaded the layers of the stomach wall, nearby lymph nodes, and nearby organs. It can also be given before surgery to shrink a tumour.
Radiation is most commonly used in combination with chemotherapy.